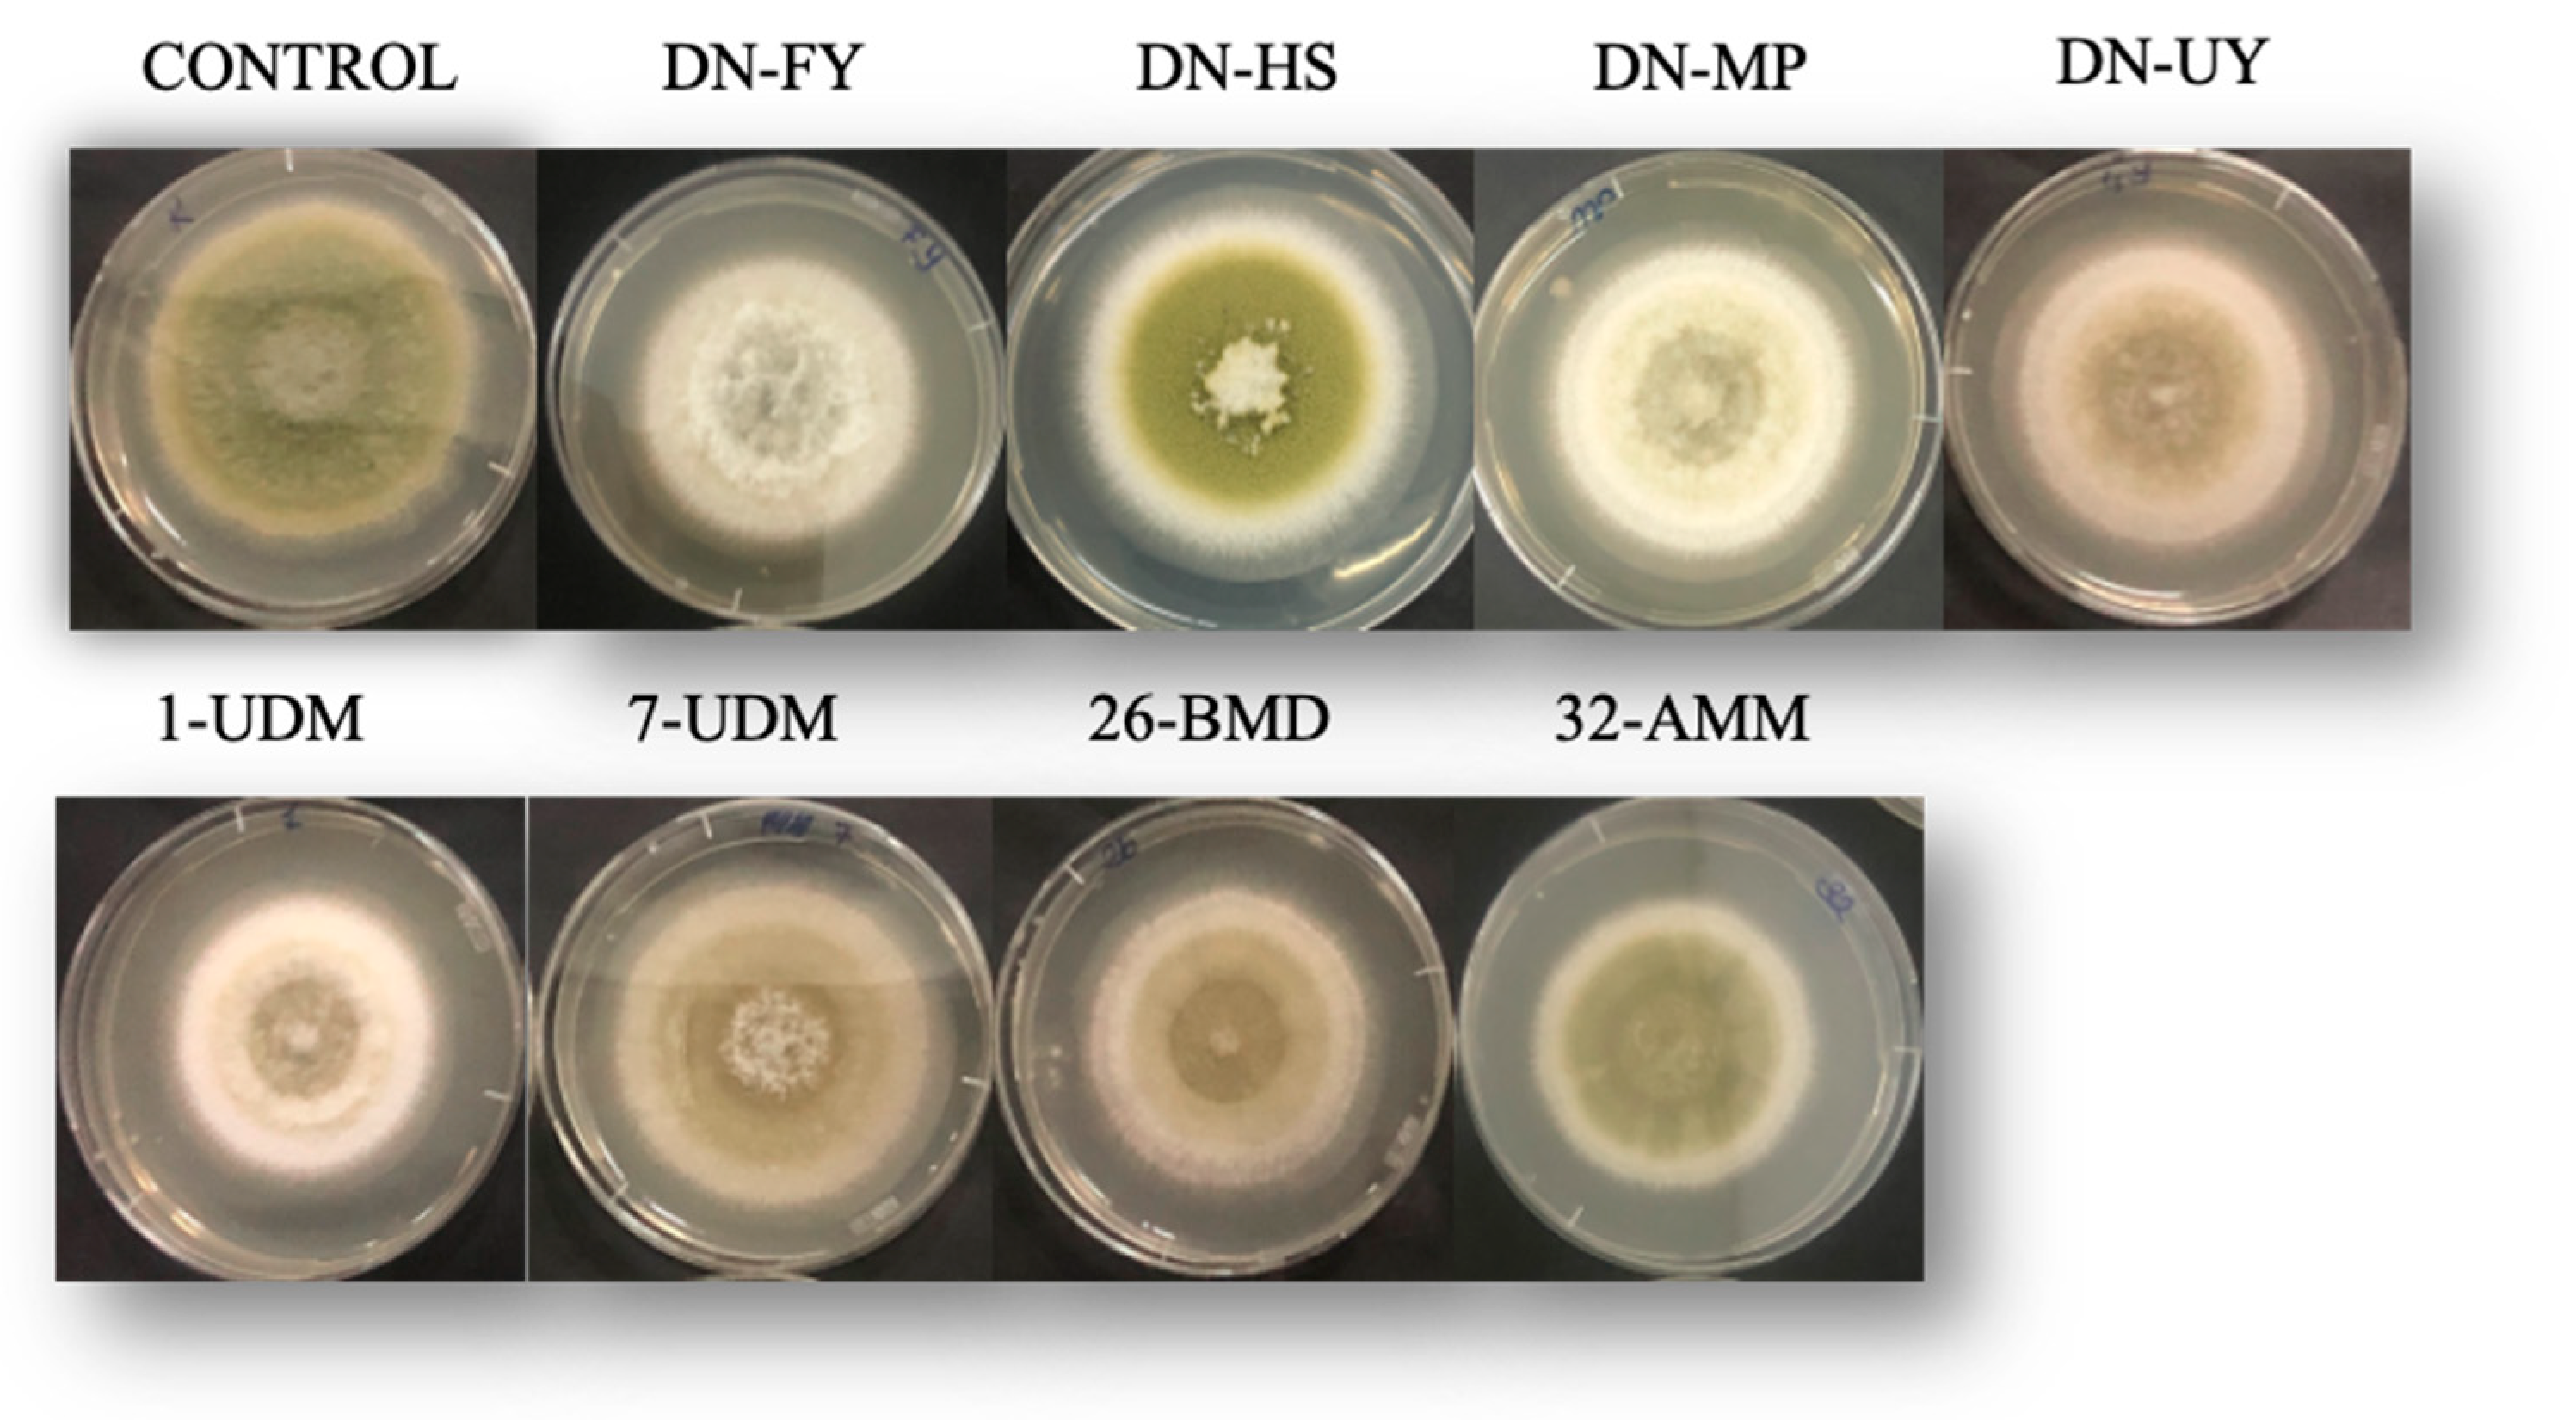
Toxins 15 00402 g003 Toxins 15 00402 g003
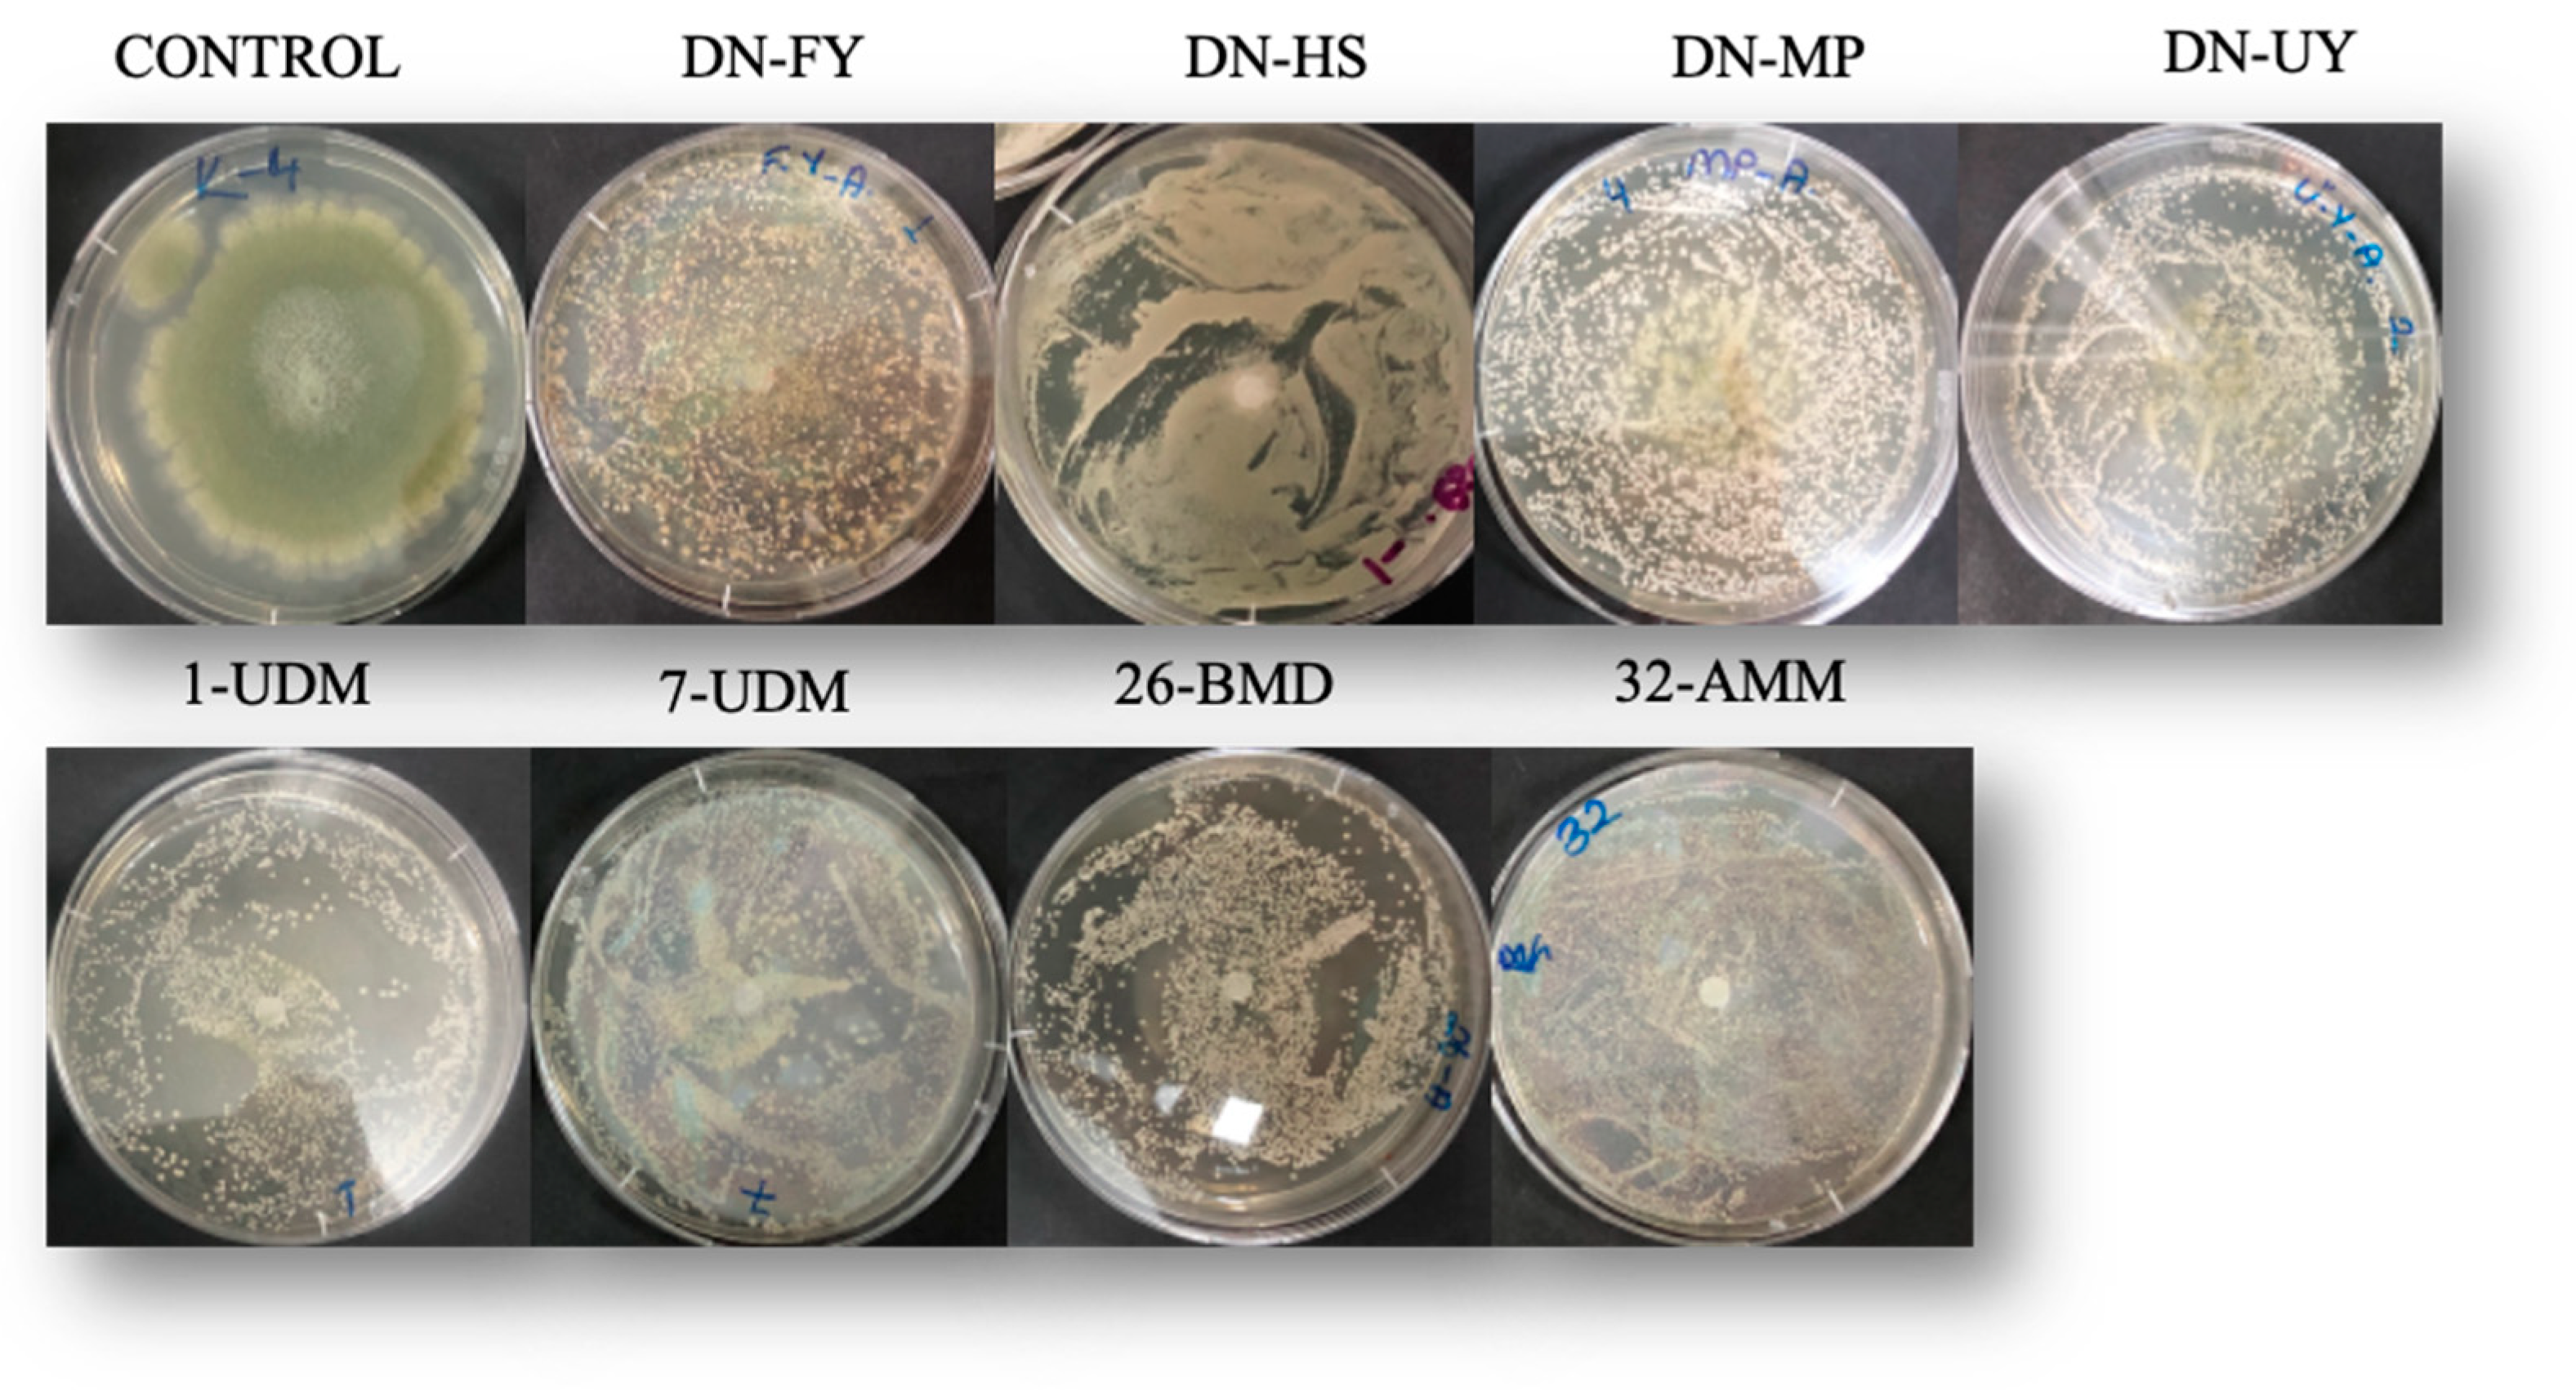
Toxins 15 00402 g004 Toxins 15 00402 g004

Abstract
Aspergillus flavus is a major aflatoxin B1, posing significant health concerns to humans, crops, and producer fungi. Due to the undesirable consequences of the usage of synthetic fungicides, biological control using yeasts has gained more attention. In this study, eight isolates of epiphytic yeasts belonging to Moesziomyces sp., Meyerozyma sp. and Metschnikowia sp., which have been identified as antagonists, were isolated from different plants, including grapes, blueberries, hawthorns, hoşkıran, beans and grape leaf. While volatile organic compounds (VOCs) produced by Moesziomyces bullatus DN-FY, Metschnikowia aff. pulcherrima DN-MP and Metschnikowia aff. pulcherrima 32-AMM reduced in vitro A. flavus mycelial growth and sporulation, only VOCs produced by Metschnikowia aff. fructicola 1-UDM were found to be effective at reducing in vitro AFB1 production. All yeasts reduced the mycelial growth of A. flavus by 76–91%, while AFB1 production reduced to 1.26–10.15 ng/g and the control plates’ growth was 1773 ng/g. The most effective yeast, Metschnikowia aff. Pulcherrima DN-HS, reduced Aspergillus flavus growth and aflatoxin B1 production on hazelnuts. The AFB1 content on hazelnuts reduced to 333.01 ng/g from 536.74 ng/g. To our knowledge, this is the first report of yeasts isolated from plants being tested as potential biological control agents to reduce AFB1 production on hazelnuts.
Keywords:
Aspergillus spp.; aflatoxin; mycotoxin; biocontrol; antagonistic yeast; volatile organic compounds; hazelnut Key Contribution:
This in vitro study reported that antagonistic yeasts significantly inhibited Aspergillus flavus growth and reduced AFB1 production. Metschnikowia aff. pulcherrima DN-HS was effective at reducing A. flavus growth and AFB1 production on hazelnuts.
1. Introduction
Mycotoxins are toxic metabolites produced by fungi, particularly saprophytic molds that grow on agricultural products. They are harmful to human and animal health and cause economic losses and reduce crop quality [1]. Aflatoxin, a significant mycotoxin of concern in agriculture, is mainly produced by Aspergillus flavus and Aspergillus parasiticus [2]. Various crops, such as maize (Zea mays L.), groundnut (Arachis hypogaea L.), cottonseed (Gossypium spp.), pistachio (Pistacia vera L.) and almond (Prunus dulcis Mill.) are prone to contamination by aflatoxin-producing fungi under both pre and post-harvest conditions [3]. Aflatoxins can pose significant health concerns to humans and animals and have been identified as a serious food safety concern [4], as well as being classed as group 1 carcinogens by the International Agency for Research on Cancer [5]. Aflatoxins, which are grouped into 20 chemically related metabolites, are of four major types: aflatoxins B1, B2, G1 and G2 (AFB1, AFB2, AFG1 and AFG2) [6]. In Turkey, aflatoxin occurs most commonly on dried figs, pistachios, hazelnuts, and groundnuts [7]. Turkey’s national legislation on mycotoxins is in line with EU standards. The maximum levels in various nuts, grains and different fruits and spices are in the range of 2 μg/kg–12 μg/kg for AFB1 and 4 μg/kg–15 μg/kg for the sum of aflatoxins [8]. Crop contamination with aflatoxin has significant indirect and direct economic effects. The loss of produce or market value, medical expenses, and related costs are examples of the direct economic impact. Animal losses and the cost of preventing and monitoring food-borne illnesses are just two examples of indirect economic effects [1]. Due to crop losses brought on by mycotoxigenic fungi like A. flavus, these regulatory guidelines (applied both domestically and internationally) have placed a significant financial burden of over US$932 million on agriculture worldwide. Depending on the market, economic losses could reach 100% due to the product being completely rejected when aflatoxin levels exceed acceptable limits. Due to requirements to comply with EU standards for all food exports, Africa alone loses more than US$670 million annually [1].
Hazelnuts are a significant export for Turkey. According to Alasalvar, Amaral, and Shahidi [9], hazelnut kernels are very nutrient-dense due to their high concentrations of fats (particularly oleic acid), proteins, carbohydrates, dietary fiber, vitamins (especially vitamin E), minerals, tocopherols (α-tocopherol), phytosterols (β-sitosterol), polyphenols, and squalane. Hazelnut is one of the most widely grown nut crops worldwide, with Turkey and Italy leading the world in production (665,000 tons and 140,560 tons, respectively), with a market share that is constantly expanding [10]. The existence and expansion of aflatoxigenic fungi, which can result in the production of aflatoxins and the contamination of hazelnuts, is a significant obstacle to the hazelnut industry. Aflatoxigenic fungi can infect hazelnuts in the orchard before harvest, during harvest, and especially during storage after the shell has been cracked [11].
AFB1 is known as the most carcinogenic, mutagenic, and teratogenic substance that naturally presents in foods and feeds [12]. As a result, detecting and preventing contamination by Aspergillus species, as well as reducing the level of aflatoxins in grains used in many agricultural products, is critical [2]. In addition to political pressure to remove hazardous pesticides from the market, the use of chemical pesticides has been restricted [13]. Therefore, a better alternative is needed to manage and detect aflatoxin producers in their early stages of growth. To reduce synthetic fungicide application, biological control with microbial antagonists has emerged as a promising alternative due to being environmentally safe and sustainable [14]. Among bacteria, members of the genera Bacillus sp. can control Aspergillus sp. growth [15,16]. Applying competitive and non-aflatoxigenic strains of A. flavus and A. parasiticus to soil has been shown to be an effective technique for preventing pre-harvest aflatoxin contamination of crops among aflatoxin contamination management approaches by several studies [6,17,18].
Yeast has become more interesting due to some characteristics that could be used as biocontrol agents, including growing faster than fungal pathogens, simple nutritional requirements and the ability to colonize dry surfaces of several niches to compete for nutrients and space [19]. In addition, yeasts are recognized as harmless to humans in the absence of allergenic spore production [20]. Besides important characteristics, including their efficacy against phytopathogenic fungi, yeasts may become a promising alternative to synthetic fungicides among various microorganisms that have already been reported by several studies [14,21,22,23]. The management of fungal contamination by antagonistic yeasts has been described by several mechanisms such as competition for space and nutrients, biofilm formation, parasitism, production of diffusible antimicrobial compounds, antibiosis, lytic enzyme production, and production of antimicrobial volatile organic compounds (VOCs). The antifungal activity of the VOCs produced by yeast isolates was documented against Botyrtis cinerea [24,25]; Aspergillus carbonarius [23]; Penicillium expansum and Penicillium digitatum [26]. Recent studies have investigated the ability of antagonistic yeasts to inhibit or reduce Ochratoxin A (OTA) [27,28]. However, studies investigating yeasts’ and yeast VOCs’ abilities to control A. flavus growth and aflatoxin B1 production are limited.
The antagonistic impact of Metschnikowia spp. on various molds has been extensively documented, including Penicillium spp. [20], Alternaria spp., Aspergillus spp., Fusarium spp. [29] and Botrytis cinerea [30]. Additionally, it is well documented that the antagonistic effect of Meyerozyma guilermondii (previously known as Pichia guilermondii) on different post-harvest pathogens significantly affects fruit and vegetables [31,32,33]. However, biocontrol ability is not a general characteristic of Moesziomyces (previously known as Pseudozyma), which is an environmental yeast commonly isolated from plant leaves, flowers and soil [20]. Recently, M. pullcherima was found to effectively control green mold disease on mandarin [34] and Botrytis cinerea infection in apples [35]. M. guilermondii was effective at controlling gray mold on kiwi fruit [36]. Parafati et al. [37] documented that M. pulcherrima could be considered a biocontrol agent for controlling A. flavus contamination on pistachio nuts. Few studies have focused on the decontamination of Aspergillus spp. or aflatoxins on hazelnuts using low-pressure (LP) [38], atmospheric-pressure (AP) plasmas [38,39], cold plasma [40] and diffuse barrier discharge [41]. However, based on our literature review, there is no information on the control of the growth of A. flavus or other molds and on AFB1 production on hazelnuts using a biocontrol agent.
This study aimed to isolate and identify the yeasts, determine their biocontrol capabilities against the growth of A. flavus and its AFB1 production and evaluate the most effective antagonistic yeast for controlling A. flavus growth and AFB1 production on hazelnuts.
2. Results
2.1. Isolation and Molecular Identification of Yeast Isolates
Eight yeasts were isolated from hawthorn, bean leaves, corn tassel, and hoşkıran; four of them were selected and identified by PCR amplification and sequencing the 16s rDNA gene. In this study, four Metschnikowia aff. pulcherrima, one Metschnikowia aff. fructicola, one Metschnikowia pulcherrima, one Meyerozyma guilliermondii and one Moesziomyces bullatus were used (Table 1).
Table 1.
Molecular identification of yeast isolates by comparing the genomic sequences in the GenBank database using the BLAST algorithm. Yeasts marked with * were isolated and identified in a previous study by Oztekin and Karbancioglu-Güler [42].
A phylogenetic tree was constructed with reference strains of Metschnikowia sp., Meyerozyma guilliermondii and Pseudozyma species using the neighbour joining method [43]. Phylogenetic distances were computed using the maximum composite likelihood method [44] implemented in MegaX [45]. The percentage of replicate trees in which the associated taxa clustered together in the 1000 bootstrap replicates are shown next to the branches. The evolutionary distances were computed using the Maximum Composite Likelihood method. Branch lengths are proportional to nucleotide differences, as indicated on the bar. Reference sequences were retrieved from GenBank under the accession numbers indicated. Evolutionary analyses were conducted in Mega X (Figure 1).
Figure 1.
Phylogenetic tree of the yeast isolates generated using the neighbour-joining method. The percentage of replicate trees in which the associated taxa clustered together in the 1000 bootstrap replicates are shown next to the branches. The evolutionary distances were computed using the Maximum Composite Likelihood method. Branch lengths are proportional to nucleotide differences as indicated on the bar. Reference sequences were retrieved from GenBank under the accession numbers indicated. Evolutionary analyses were conducted in Mega X.
2.2. Antagonistic Activity on Agar Plates
The dual culture assay was used for preliminary screening of all yeast isolates’ antagonistic activities against the aflatoxin B1 producer A. flavus. The results showed that all isolates inhibited the mycelial growth of A. flavus. Limited fungal mycelium growth and spore production inhibition were clearly visible in the zone surrounding the Metschnikowia aff. pulcherrima DN- HS colony, which indicated inhibition (Figure S1). Mycelial growth did not exceed or reach any yeast isolates. Compared to untreated control, the colony diameter was reduced by 36–40% after 9 days of incubation (Figure 2).
Figure 2.
Biocontrol activity of eight yeast cultures (DN-HS, DN-FY, DN-MP, DN-UY, 1-UD7, UD26-BMD, 32-AMM) against A. flavus. Results are expressed as colony diameter (cm) over 9 days of incubation at 25 °C. Vertical bars indicate standard error (n = 6).
The colony diameters of cultures that interacted with Moesziomyces bullatus DN-FY, Metschnikowia aff. pulcherrima DN-MP, Metschnikowia aff. fructicola 1-UDM and Metschnikowia pulcherrima 26-BMD were statistically different on day 3 of incubation compared with other incubation periods (p < 0.05). However, control plate colony diameters were statistically different over the incubation period. Additionally, after 9 days of incubation, fungal colony diameters of all yeast isolates were statistically different from the control plates. Results are expressed as colony diameters (mm) over 9 days of the incubation period (Table 2).
Table 2.
Biocontrol activity of eight yeast isolates against A. flavus.
2.3. Effects of Volatile Organic Compounds (VOCs)
According to studies, the production of antifungal VOCs by M. aff. pulcherrima DN-HS, M. guilliermondii 7-BYMD and M. pulcherrima 26-BMD had no significant impact on mycelium growth inhibition compared with control plates after 7 days of incubation. There were significant differences between M. bullatus DN-FY, M. aff. pulcherrima DN-MP and M. aff. pulcherrima 32-AMM on the 7th day compared with other yeast cultures (Table 3). M. bullatus DN-FY, M. aff. pulcherrima DN-MP and M. aff. pulcherrima 32-AMM isolates showed the highest antagonistic activity, with mycelial growth reduction of 12.49%, 11.8% and 11.07%, respectively. Additionally, higher inhibition rates were observed for M. bullatus DN-FY isolates during all incubation periods. However, mycelial growth inhibition rates were highest on day 3 of incubation for all of the yeast isolates. Volatile organic compounds’ effects decreased after the long incubation period.
Table 3.
The effect of volatile organic compounds produced by eight antagonistic yeasts against A. flavus after 3, 5 and 7 days of incubation.
Morphological changes were observed due to the effect of VOC treatment (Figure 3). Additionally, evidence of the images is only colony growth changes of the fungal mycelium due to the effect of the volatile compounds. However, sporulation of the fungal growth was significantly decreased by the volatile organic compounds from all the yeast cultures, apart from M. aff. pulcherrima DN-HS isolate, as seen in Figure 3. Moreover, in the presence of M. bullatus DN-FY, M. aff. pulcherrima DN-MP and M. aff. fructicola 1-UDM, colonies of A. flavus were characterized by white mycelium. Additionally, compared with other yeast cultures, the most effective VOCs were produced by M. bullatus DN-FY, which mainly reduced sporulation. However, M. aff. pulcherrima DN-HS was not effective at inhibiting A. flavus production and showed similar morphological changes to the control plates.
Figure 3.
A. flavus cultured plates covered with VOCs produced by yeast cultures after 7 days of incubation.
2.4. Radial İnhibition of A. flavus
The yeasts that were most effective at inhibiting mycelial growth were M. aff. pulcherrima 32-AMM and 1-UDM. They were statistically different from other isolates and significantly reduced the mycelial growth of A. flavus (Table 4). The M. aff. pulcherrima DN-HS, M. aff. pulcherrima DN-UY and M. pulcherrima 26-BMD isolates promoted 100% inhibition after 3 days of incubation. All tested isolates significantly inhibited mycelial growth at three days of incubation compared with the other incubation periods (p < 0.05). For the eight isolates, fungal inhibition was observed within the range of 76.39–91.53% on day 7. Only M. aff. pulcherrima DN-UY mycelial growth inhibition rate was not significantly affected by the incubation period. Based on the findings, the yeast cultures were the same, but their antagonistic effects differed due to their isolation source; M. aff. pulcherrima 32-AMM was the most effective at inhibiting mycelial growth while M. aff. pulcherrima DN-MP was the least effective.
Table 4.
In vitro mycelial growth inhibition of eight yeast isolates against A. flavus.
Apart from M. bullatus DN-FY, M. aff. pulcherrima DN-MP and M. pulcherrima 26-BMD, isolates did not exceed the spot inoculation area after 7 days of incubation (Figure 4).
Figure 4.
A. flavus spot inoculated with different yeasts on PDA at 25 °C for 7 days.
2.5. Effect of Yeasts on In Vitro Aflatoxin B1 Production
Aflatoxin B1 production by A. flavus with the yeast interaction is shown in Table 5. A. flavus produced higher amounts of AFB1 without yeasts. M. aff. pulcherrima DN-HS was determined to be the most effective yeast for controlling AFB1 production (p < 0.05). When the yeast was in direct contact with fungal cultures, AFB1 production was nearly inhibited and VOCs of yeasts were ineffective at controlling AFB1 production. From this point of view, in vivo experiments on hazelnuts carried out using M. aff. pulcherrima DN-HS strain showed significant mycelial growth inhibition and the highest reduction in AFB1 production based on the in vitro assay, and was statistically significant compared with other yeast strains.
Table 5.
Effects of yeasts on AFB1 production after 3, 5 and 7 days of incubation at 25 °C.
Based on the aflatoxin analysis results, only VOCs from M. aff. fructicola 1-UDM were effective at controlling AFB1 production by A. flavus (Table 6), while other isolates’ VOCs were either ineffective or promoted AFB1 production. VOCs from M. aff. fructicola 1-UDM reduced AFB1 production by 83%, 57% and 40% after 3, 5 and 7 days of incubation, respectively. The effects of VOCs on aflatoxin B1 were significantly decreased after three days of incubation. However, as can be seen from the results, there was no link between mycelium growth inhibition and AFB1 reduction. The average concentrations of AFB1 in the control plates (without exposure to VOCs) were 3040.89 ng/g, 4008.93 ng/g and 3265.02 ng/g after 3, 5 and 7 days of incubation, respectively. In control plates, aflatoxin B1 production was highest at 5 days of incubation at 25 °C. However, in aflatoxin B1 analysis, a higher standard deviation was observed from different replicates.
Table 6.
Effects of M. aff. fructicola 1-UDM VOC’s impact on AFB1 production and colony diameter of A. flavus after 3, 5 and 7 days of incubation at 25 °C.
2.6. Biocontrol Activity of Antagonistic Yeasts on Hazelnuts
Based on the results of in vitro studies, Metschnikowia aff. pulcherrima DN-HS was selected to investigate the in vivo effect on A. flavus growth and its aflatoxin B1 production. The results of Aspergillus flavus counts and AFB1 levels on hazelnuts treated with Metschnikowia aff. pulcherrima DN-HS yeasts are shown in Table 7.
Table 7.
Effect of antagonistic yeast on Aspergillus flavus growth on hazelnuts after 3, 5 and 7 days of incubation.
Compared with the control samples, antagonistic yeast treatments reduced A. flavus counts on hazelnuts by 46%, 51% and 35% after 3, 5 and 7 days of incubation, respectively. However, the effect of antagonistic yeast was highest on the 5th day of incubation. After 7 days of incubation, the samples treated with antagonists showed a slight difference in the fungal count compared with the control. The fungal counts were similar on the 5th and 7th days of incubation. A similar impact was shown in reducing AFB1 production. AFB1 content was significantly reduced by antagonistic yeasts at all incubation periods (Figure 5). Antagonistic yeast reduced AFB1 content on hazelnuts by 19, 46 and 38% at 3, 5 and 7 days. The antagonistic yeast was less effective at 7 days of incubation than at 5 days of incubation.
Figure 5.
Hazelnut samples treated with M. aff. pulcherrima DN-HS; AFB1 content after different incubation periods. * Average values that are significantly different from the control based on the t-test (p < 0.05) are indicated by an asterisk in each column.
3. Discussion
In most cases, microbial antagonists are isolated from natural environments or the surfaces of living plant parts [16]. The study’s primary aim was to isolate and identify the yeast isolates from plant parts collected from Turkey to evaluate their antifungal and anti-aflatoxigenic activity through in vitro studies. Because of their biological and non-toxic properties, yeasts stand out among the microorganisms considered potential biological control agents [34]. Researchers have generally investigated the control of OTA production by microbial antagonists using in vitro and in vivo studies [21,23,46,47].
Aspergillus flavus causes grain degradation and yield loss. It is the main producer of aflatoxins with hepatotoxic, genotoxic, and teratogenic characteristics. High occurrence rates of aflatoxins were reported in rice, maize, nuts, wheat, cereals, dried fruits, and spices [48]. To our knowledge, this study is the first to report on yeasts of Metschnikowia sp., Meyerozyma sp. and Moezymyces (Pseudozyma) sp. with antagonistic activity against A. flavus and AFB1 production, although the biocontrol capabilities of bacterial species such as Bacillus subtilis, Bacillus megaterium, Bacillus safensis, and Pseudomonas spp. have been investigated under laboratory conditions [15,16,49]. However, these microorganisms were ineffective under field conditions [50]. Nowadays, to prevent aflatoxin production, non-aflatoxigenic A. flavus strains are used as antagonists [6]. Aflatoxin contamination was reduced by 70–90% in peanuts and cotton using non-toxigenic Aspergillus strains. However, researchers have also tried developing biocontrol agents for reducing aflatoxin contamination in the field [2].
A dual culture assay was initially used to screen yeast isolates’ antagonistic effect. The dual assay showed that all isolates of M. aff. fructicola, M. pulcherrima, M. guilermondii and Moezymyces bullatus have an antagonistic effect on the aflatoxin B1 producer A. flavus. These yeasts’ antagonistic effects against different fungal strains were documented by researchers [20,22,51,52,53]. Mycelial growth was restricted and yeast strains formed an inhibition zone in dual culture assays. In Israel, one strain of M. fructicola was registered to protect commercial postharvest fruits and vegetables [54]. It has been previously documented that the mechanism of action of Metschnikowia spp. is based on competition for nutrients such as iron, which is essential for fungal growth and depletion, and on the release of hydrolases [29]. Direct parasitism is an important component of the Pseudozyma antarctica biocontrol strategy [20]. Some Pseudozyma spp. exhibit antifungal activity due to the synthesis of ustilagic acid, a glycolipid active against various yeasts and yeast-like and filamentous fungi [55,56].
Numerous yeasts can produce volatile organic compounds (VOCs), and the volatiles have been linked to their antagonistic activity [23]. Several studies have been conducted on the production of VOCs by M. pulcherrima [14], M. fructicola [57] and M. guilermondii [58] against fungi. In this study, the highest antifungal activities of VOCs produced by M. bullatus DN-FY, M. aff. pulcherrima DN-MP and M. aff. pulcherrima 32-AMM were observed. On the other hand, A. flavus growth in the presence of some yeasts showed similarity with the absence of yeasts. Based on the literature review, there is no published information regarding aflatoxin B1 reduction by VOCs produced by yeasts. However, it has been widely reported that non-aflatoxigenic Aspergillus spp.’s VOCs are effective at reducing aflatoxin B1 production using the 2,3-dihydro-furan, trans-2- methyl-2-butenal, and 3-octanone [59]. Ethyl acetate [60] and ethyl alcohol [24] are the main VOCs that are naturally produced by M. pullcherima. The volatile antifungal metabolites produced by M. guilermondii include alcohols, aldehydes, hydrocarbons and terpenes [18]. Similar to our results, a study by Liu et al. [20] reported that Metschnikowia citriensis volatile organic compounds have more significant antagonistic activity against P. Digitatum and Penicillium italicum, with 3.17–11.36% of mycelium growth inhibition. Additionally, Pseudozyma antarctica VOCs showed a 5.38–7.47% reduction. Furthermore, in another study, M. pulcherrima VOCs reduced the mycelial growth of A. carbonarius by 6.5 ± 0.9% [60]. In a recent study, the same M. aff. fructicola 1-UDM isolate used in this study showed slightly higher mycelial growth inhibition against P. digitatum (28.44%) and P. expansum (19.88%) [41].
Similar to our findings, VOCs released by Cyberlindnera jadinii, Candida friedrichii, Candida intermedia and Lachancea thermotolerans prevent the sporulation of A. carbonarius [23]. Moreover, the noted inhibition of sporulation is consistent with the findings of Ul Hassan et al. [61] and Farbo et al. [23]. After a long incubation period, a reduction in mycelial growth inhibition was observed. This may be explained by a reduction in antifungal compounds. The reduction in volatile organic compounds emitted by M. pulcherrima was also reported after 5 days of incubation [62]. Additionally, Di Francesco et al. [26] stated that Aeureobasidium pullulans VOCs were emitted in the first 4 days of incubation and began to decrease after 4 days.
Studies on Meyerozyma sp. VOCs are limited and there are no studies on Moezymyces VOCs. In line with our findings, M. guilliermondii VOCs reduced mycelial growth of P. expansum by 13.67% and 18.9% at pH 4.5 [58]. Al-Maawali et al. [63] reported that VOCs produced by M. guilermondii reduced Alternaria alternata growth through production of tricosane and pentacosane.
The present study showed that M. aff. fructicola 1-UDM VOCs were the most effective yeasts for reducing mycelial growth and sporulation of A. flavus. AFB1 production by A. flavus MRC200744 was only reduced by VOCs of M. aff. fructicola 1-UDM. Similar to our results, despite the significant antagonistic effect on A. flavus growth, exposing the fungi to two S. cerevisiae strains did not show an effect on aflatoxin synthesis potential [61]. However, little information exists on Moezmyces (Pseudozyma) and Meyerozyma sp., and their mechanism of action should be investigated.
Different from the effect of VOCs, all studied isolates inhibited A. flavus growth and AFB1 production based on the spot inoculation method. M. aff. fructicola 1-UDM and M. aff. pulcherrima 32-AMM yeasts were the most effective at inhibiting mycelial growth. Similarly, Shude et al. [64] found that Pseudozyma sp. was effective at reducing Fusarium gramineraum mycelial growth and DON concentration. Oztekin and Karbancıoglu-Guler [60] documented that M. aff. fructicola 1-UDM and M. aff. pulcherrima 32-AMM had a strong antagonistic effect against F. oxysporum, B. cinerea, P. digitatum, P. expansum and A. alternate, similar to our findings.
Pawliowska et al. [65] stated that Metschnikowia sp. showed a strong antagonistic effect against Alternaria, Botrytis, Fusarium and Rhizopus. Reduction of some mycotoxins such as ochratoxin A [66] and patulin [67,68] by Metschnikowia sp. has been reported. Researchers have studied antagonistic yeasts in fruits such as apples [51], grapes [46] and strawberries [24] using in vivo studies. The effect of antagonistic microorganisms on aflatoxin production by Bacillus sp. in maize [15] and pistachio [69]; by aflasafe products in groundnuts and maize [3]; and by bacterial strains in corn [70] has been studied. Einloft et al. [15] reported that aflatoxin B1 production was reduced by 44.5–89.7% by different Bacillus sp. In another study, B. amyloliquefaciens and B. subtilis were found to be effective at reducing aflatoxin production on pistachio by Aspergillus parasiticus strain after 5 and 8 days of incubation. However, they reported that antagonists were ineffective at controlling aflatoxin after 12 days of incubation [69]. Metschnikowia aff. pulcherrima DN-HS strains grew faster than Aspergillus flavus. From this perspective, higher biocontrol efficiency was observed at 5 days, similar to the study by Siahmoshteh et al. [69] because yeast cultures reached a stationary phase while the fungus continued to proliferate. Additionally, different antagonistic bacteria inhibited A. flavus growth on pistachio by 45–70.5%. However, some of them were not effective at inhibiting the production of aflatoxin [70]. Our investigations showed that the direct reduction of A. flavus growth and its AFB1 production on hazelnuts using Metschnikowia sp. have not been previously reported.
4. Conclusions
Aflatoxin, which is produced predominantly by Aspergillus flavus and Aspergillus parasiticus, is one of the most important mycotoxins of concern in agriculture. Several food commodities have been infected at pre and post-harvest stages by this mycotoxin, including hazelnuts, pistachios, dried figs and maize. Generally, synthetic fungicides are used to control fungal growth and mycotoxin production. However, yeasts and bacteria have been extensively studied as biocontrol agents. For these reasons, in this study, antagonistic yeasts were isolated and shown to control Aspergillus flavus growth and aflatoxin B1 production. Furthermore, yeast cultures and their volatile organic compounds’ efficiency to control Aspergillus flavus growth and aflatoxin B1 production were investigated through in vitro studies. A. flavus growth and AFB1 production were significantly restricted by all tested yeasts that came in contact with the fungal strains. On the contrary, only M. aff. fructicola 1-UDM VOCs reduced AFB1 production. Based on the in vivo studies, M. aff. pulcherrima DN-HS was found to be effective at inhibiting A. flavus growth and AFB1 production on hazelnut samples. Future studies will address the increased in vitro efficacy of yeast against A. flavus growth and AFB1 production using preventative and curative treatments with practical spray applications. Furthermore, yeast strains might be combined with an agent to increase efficacy and the most crucial step, the hazelnut quality, might be investigated.
Our findings revealed that these species can also play an important role as biocontrol agents against A. flavus growth and AFB1 production on hazelnuts, and will be explored in further studies.
5. Materials and Methods
5.1. Pathogen
A. flavus MRC 200744 (AFB1 producer) was obtained from TUBITAK MAM Food Institue Culture Collection, Turkey, on slant agar media. Mold culture was grown on potato dextrose agar (PDA, Merck, Darmstad, Germany) at 25 °C; their stock solutions were prepared in 20% (v/v) glycerol and subsequently kept at −80 °C for antagonism tests.
5.2. Isolation of Yeast Cultures
The yeasts from grapes and blackberries were isolated and identified by Oztekin and Karbancıoğlu-Güler [42]. The yeasts were isolated from hawthorn, bean leaves, corn tassel and hoşkıran collected from Ordu/Turkey. The samples were kept in polyethylene bags and stored at −80 °C until yeast isolation. Approximately 5 g of the sample was incubated in an Erlenmeyer flask on a rotary shaker at 150 rpm in 50 mL of Tryptic Soy Broth (TSB) at 25 °C for 2–3 days. Following the incubation, decimal solutions were prepared with 0.85% saline solution, and 100 µL of the medium was then spread over malt extract agar (MEA) supplemented with 0.01% chloramphenicol. After incubation at 25 °C, single-cell colonies of the cultures were obtained from the MEA using the streak plate method, with 0.01% chloramphenicol, and incubated at 25 °C for 3 days. The colonies’ cell morphology was observed under a light microscope. Each yeast culture was kept at 4 °C in yeast extract peptone dextrose (YEPD) agar medium (10 g/L yeast extract, 20 g/L, peptone, 20 g/L glucose, 20 g/L agar) slant and 20% glycerol stock at −80 °C until further analysis.
5.3. Identification of Yeasts
Yeasts were identified by sequencing the universal ITS1-5.8S-ITS2 (ITS AB28: (5′-ATA TGC TTA AGT TCA GCG GGT-3′) and ITS-TW81 (5′-GTT TCC GTA GGT GAA CCT GC-3′) primers. The primers were obtained from Sentiolab, Turkey. DNA extraction was performed using the Intron G-Spin DNA extraction kit (catalogue number 17045).
PCR analysis was conducted using 5 μL of Mg free Taq DNA polymerase buffer, 3 μL of MgCl2 (25 mM), 5 μL × 10 of deoxynucleotide triphosphates (2 mM each), 10 picomole/μL of each universal primer and 1.25 U Taq DNA polymerase (Thermo Scientific, EP0402, Vinius, Lithuania). PCR analysis was performed via the following steps: pre-denaturation for 5 min at 95 °C; 35 denaturation cycles carried out for 1 min at 95 °C; annealing was carried out for 1 min at a temperature suitable for each primer pair; extension was carried out for 1 min at 72 °C; and the final extension was carried out for 10 min at 72 °C. PCR products were separated by electrophoresis on agarose 3% (w/v) gels, photographed using a Vilber Lourmat Transilluminator, and purified using an Exo-SAP purification kit. DTCS cycle sequencing kit was used for DNA sequencing reactions and phylogenetic analysis. PCR products were analysed using ABI 3500 XL Genetic Analyzer (Applied Biosystems, Carlsbad, CA, USA). In order to differentiate fungal species, forward and reverse sequences obtained from Sanger sequencing were compared with NCBI Blast and aligned in BioEdit sequence alignment editor 7.2.5 software. Phylogenetic distances were computed using the Neighbour-joining method in MEGA-X version 10.2.2. The sequences obtained were compared to those included in the GenBank database using the Basic Local Alignment Search Tool (BLAST, http://www.ncbi.nlm.nih.gov (accessed on 11 September 2021)). The GenBank accession numbers of the sequences generated in this study are shown in Table 1.
5.4. In Vitro Assays
5.4.1. Antagonistic Activity on Agar Plates
The mold strain A. flavus MRC 200744 was grown on PDA for 5–7 days at 25 °C. A pure suspension of A. flavus was then harvested in Ringer’s solution supplemented with 0.1% Tween 80 from PDA. The spore suspension was counted and adjusted to the desired concentration of 1 × 108 spores/mL using a haemocytometer.
The yeasts were grown on YEPD agar (10 g/L yeast extract, 20 g/L, peptone, 20 g/L glucose, 20 g/L agar) slant and preserved at 4 °C until use. Yeast cultures were grown on YEPD broth (10 g/L yeast extract, 20 g/L, peptone, 20 g/L glucose) and incubated at 25 °C for 2 days before analysis. The interaction between yeast and A. flavus was evaluated using the dual culture method with minor modifications [21]. First, 100 µL of yeast suspension (1 × 107 cells/mL) was streaked as a line 3 cm away from the PDA agar Petri plates edge (90 mm). After 48 h of incubation at 25 °C, 5 µL (105 conidia/mL) of the spore suspension of A. flavus was spot inoculated 30 mm away from the yeast inoculation. Control Petri dishes were only inoculated with A. flavus spore suspension. The colony diameter on control plates reached 30 mm after 7 days of incubation at 25 °C.
5.4.2. Effects of Volatile Organic Compounds (VOC)
A double Petri dish assay was used to investigate the efficacy of VOCs from each yeast against A. flavus as described by Ruiz Mayona et al. [24] and Parafati et al. [14], with slight modifications. Aliquots of 100 µL of yeast suspensions (1 × 107 cell/mL) were spread on Petri plates containing YEPD agar and incubated for 48 h at 25 °C. Aliquots of 5 µL spore suspension (1 × 106 spore/mL) were inoculated on the centre of the PDA Petri plates and dried at room temperature. Double dish assay was performed without inoculation of yeast for control plates. The lids of the petri dishes were then removed and the plates were covered and sealed with parafilm to avoid air leakage and incubated at 25 °C for 7 days. The diameter of the mycelia was measured daily. Reduction in A. flavus radial growth was calculated after 7 days. All analyses for each isolate were performed in quadruplicate and repeated three times.
5.4.3. Radial Inhibition Assay of A. flavus
The antagonistic potential of yeast cultures against A. flavus was assessed using an agar plate inhibition assay as described by Medina-Córdova et al. [19]. A total of 100 µL of 1 × 107 cells/mL suspension of yeast isolates was seeded on the PDA plates. After drying at room temperature, aliquots of 10 µL of the spore suspension (1 × 106 cells/mL) were pipetted onto the centre of PDA plates and incubated for 7 days at 25 °C. The diameter of each colony was measured to calculate the radial inhibition (RI). The radial inhibition rate (RI) was calculated as follows:
where C (control) was the average diameter of fungal colonies in the absence of yeast isolates and T (treatment) was the average diameter of fungal colonies in the presence of yeast. Each treatment had four replicates and was performed three times.
RI (%) = [(C − T)/C] × 100
5.4.4. Aflatoxin B1 Extraction from Medium
The effects of yeasts and their VOCs on aflatoxin B1 production were analyzed and plates were prepared as indicated in Section 2.5 and Section 2.6. In a preliminary experiment, a time course of mycelium growth and AFB1 production by A. flavus cultured on PDA at 25 °C was assessed by evaluating the radial growth and analyzing 3 plugs cut from duplicate colonies at 3, 5 and 7 days, and repeated twice. Aflatoxin B1 production by A. flavus in the presence of yeast was evaluated after 3, 5 and 7 days of incubation, as described by Bragulat et al. [71] and Farbo et al. [23]. Three agar plugs (6 mm in diameter) from the medium were removed with a sterile cork borer across the diameter of the agar plug in this approach. Samples were weighed and transferred to a 2.0 mL Eppendorf tube, 1.5 mL of methanol was added and the tubes were shaken slowly. After that, tubes were kept at room temperature for 1 h and centrifuged at 10,000 rpm for 5 min. The supernatants were transferred into a 0.22 µm centrifuge tube filter (Costar, Spin-X, Corning Incorporated, Corning, NY, USA) and again centrifuged at 10,000 rpm for 5 min. The supernatants were then transferred to a vial and preserved at 4 °C prior to analysis.
5.5. In Vivo Assays
5.5.1. Sample Preparation
In vivo biocontrol ability of Metschnikowia aff. pulcherrima DN-HS, the most effective isolate for reducing aflatoxin B1 production in in vitro studies, was investigated on hazelnuts. Raw hazelnuts, supplied from Gürsoy A.Ş. (Ordu, Turkey), were vacuum-packed in non-permeable polyethylene bags and stored at −20 °C before analysis. First, hazelnut samples were rinsed with tap water. Then seeds were disinfected with sodium hypochloride for 2 min. Excess sodium hyphochloride was removed by rinsing with sterile distilled water and the seeds were finally dried under a laminar flow cabinet for several hours [19]. Sterilized hazelnut samples (50 g) were immersed for 30 min in yeast suspension (1 × 108 cells/mL) under constant agitation. The control samples were immersed in the solution. Then hazelnut samples were dried. Finally, hazelnut samples were dipped into spore suspension 1 × 106 spores/mL for 5 min and dried under a laminar flow cabinet. After that, the samples were incubated at 25 °C for 3, 5 and 7 days. All analyses were performed in triplicate.
5.5.2. Effect of Antagonistic Yeast against A. flavus Growth on Hazelnuts
After each incubation period, 10 g of hazelnut samples were diluted and shaken in 90 mL of 0.1% Tween 80 at 200 rpm for 6 h [37] and then plated on dichloran rose bengal chloramphenicol agar (DRBC, Merck 100466, Darmstad, Germany). The plates were incubated at 25 °C for 5 days. After the incubation period, fungal counts were determined.
5.5.3. Aflatoxin B1 Extraction from Hazelnuts
For aflatoxin analysis, 25 g of inoculated samples were homogenized with 125 mL of methanol: water (60:40, v/v) and shaken for 30 min. The extract was filtered, and 5 mL of samples were taken and mixed with 25 mL of phosphate-buffered saline (PBS) solution and cleaned through an immunoaffinity column AflaTest (VICAM, Water-town, MA, USA). The column was washed with 10 mL of water, and aflatoxins were then eluted with 1 mL of methanol and 1 mL of water. The samples were kept at −20 °C before the HPLC analysis.
5.6. Aflatoxin B1 Detection and Quantification
AFB1 content in the medium and hazelnuts was determined using High Performance Liquid Chromatography (HPLC). Reversed-phase HPLC analysis was performed on a 10AVP HPLC system (Shimadzu, Milan, Italy) equipped with an RF-10AXL fluorescence detector set at wavelengths 360 nm for excitation and 420 nm for emission (Shimadzu, Milan, Italy) using post-column derivatization (KobraCell, 100 mA) (R-Biopharm Rhone Ltd., Glasgow, UK) with an analytical column (ACE, C18 250 × 4.6 mm, 5 mm, 100 A). For AFB1 quantification, the mobile phase consisted of water/acetonitrile/methanol (6/2/3, v/v/v), 120 mg/L of potassium bromide and 350 µL /L of 4 M nitric acid. The constant flow and column temperature were set to 1 mL/min and 25 °C, respectively. A volume of 100 µL was injected to be analyzed. The AFB1 retention time was around 13–14 min, the target peak of the samples. Aflatoxin content was calculated from the calibration curves obtained using aflatoxin standard solutions. For AFB1, LOD = 0.004 μg/mL, LOQ = 0.013 μg/mL and the mean recovery was 93%.
5.7. Statistical Analysis
All experiments were analyzed using SPSS 22.0 (SPSS Inc., Chicago, IL, USA), with the expression mean ± standard deviation. Different yeast isolates were compared using a one-way analysis of variance (ANOVA) test. Additionally, Tukey’s multiple range test was used to assess separations and differences were considered significant at p < 0.05. t-test was used to determine differences between treatments on hazelnut samples.
Supplementary Materials
The following supporting information can be downloaded at: https://www.mdpi.com/article/10.3390/toxins15060402/s1, Figure S1: In vitro test of antagonism of a yeast isolate against A. flavus using the dual culture technique on PDA plates after 3 (A), 5 (B) and 7 (C) days of incubation with the control and DN- HS yeast interaction.
Author Contributions
Conceptualization, F.K.-G.; methodology, D.N.D.; validation, D.N.D.; formal analysis, D.N.D.; investigation, D.N.D., H.Ö. and F.K.-G.; resources, F.K.-G.; data curation, D.N.D.; writing—original draft preparation, D.N.D.; writing—review and editing, H.Ö. and F.K.-G.; visualization, D.N.D.; supervision, H.Ö. and F.K.-G.; project administration, H.Ö. and F.K.-G.; funding acquisition, H.Ö. and F.K.-G. All authors have read and agreed to the published version of the manuscript.
Funding
This research was funded by the Scientific Research Council of Istanbul Technical University, grant number MYL-2020-42498, and by the MycoTWIN project, which has received funding from the European Union’s Horizon 2020 Research and Innovation Programme under Grant Agreement No 952337.
Institutional Review Board Statement
Not applicable.
Informed Consent Statement
Not applicable.
Data Availability Statement
All the data generated for this study are included in the article.
Conflicts of Interest
The authors declare no conflict of interest.
References
- Bhatnagar-Mathur, P.; Sunkara, S.; Bhatnagar-Panwar, M.; Waliyar, F.; Sharma, K.K. Biotechnological Advances for Combating Aspergillus flavus and Aflatoxin Contamination in Crops. Plant Sci. 2015, 234, 119–132. [Google Scholar] [CrossRef]
- Mwakinyali, S.E.; Ding, X.; Ming, Z.; Tong, W.; Zhang, Q.; Li, P. Recent Development of Aflatoxin Contamination Biocontrol in Agricultural Products. Biol. Control 2019, 128, 31–39. [Google Scholar] [CrossRef]
- Agbetiameh, D.; Ortega-Beltran, A.; Awuah, R.T.; Atehnkeng, J.; Elzein, A.; Cotty, P.J.; Bandyopadhyay, R. Field Efficacy of Two Atoxigenic Biocontrol Products for Mitigation of Aflatoxin Contamination in Maize and Groundnut in Ghana. Biol. Control 2020, 150, 104351. [Google Scholar] [CrossRef]
- Accinelli, C.; Abbas, H.K.; Little, N.S.; Kotowicz, J.K.; Shier, W.T. Biological Control of Aflatoxin Production in Corn Using Non-Aflatoxigenic Aspergillus flavus Administered as a Bioplastic-Based Seed Coating. Crop Prot. 2018, 107, 87–92. [Google Scholar] [CrossRef]
- World Health Organization; International Agency for Research on Cancer (IARC). Some Naturally Occurring Substances: Food Items and Constituents, Heterocyclic Aromatic Amines and Mycotoxins. In Monographs on the Evaluation of Carcinogenic Risks to Humans; World Health Organization: Geneva, Switzerland, 1993; Volume 56. [Google Scholar]
- Alaniz Zanon, M.S.; Clemente, M.P.; Chulze, S.N. Characterization and Competitive Ability of Non-Aflatoxigenic Aspergillus flavus Isolated from the Maize Agro-Ecosystem in Argentina as Potential Aflatoxin Biocontrol Agents. Int. J. Food Microbiol. 2018, 277, 58–63. [Google Scholar] [CrossRef]
- Kabak, B. Aflatoxins in Foodstuffs: Occurrence and Risk Assessment in Turkey. J. Food Compos. Anal. 2021, 96, 103734. [Google Scholar] [CrossRef]
- European Food Safety Authority. Management of Left-Censored Data in Dietary Exposure Assessment of Chemical Substances. EFSA J. 2010, 8, 1557. [Google Scholar] [CrossRef]
- Alasalvar, C.; Amaral, J.S.; Shahidi, F. Functional Lipid Characteristics of Turkish Tombul Hazelnut (Corylus avellana L.). J. Agric. Food Chem. 2006, 54, 10177–10183. [Google Scholar] [CrossRef]
- Salvatore, M.M.; Andolfi, A.; Nicoletti, R. Mycotoxin Contamination in Hazelnut: Current Status, Analytical Strategies, and Future Prospects. Toxins 2023, 15, 99. [Google Scholar] [CrossRef]
- Kabak, B. Aflatoxins in Hazelnuts and Dried Figs: Occurrence and Exposure Assessment. Food Chem. 2016, 211, 8–16. [Google Scholar] [CrossRef]
- Nesci, A.; Passone, M.A.; Barra, P.; Girardi, N.; García, D.; Etcheverry, M. Prevention of Aflatoxin Contamination in Stored Grains Using Chemical Strategies. Curr. Opin. Food Sci. 2016, 11, 56–60. [Google Scholar] [CrossRef]
- Reddy, K.R.N.; Reddy, C.S.; Muralidharan, K. Potential of Botanicals and Biocontrol Agents on Growth and Aflatoxin Production by Aspergillus flavus Infecting Rice Grains. Food Control 2009, 20, 173–178. [Google Scholar] [CrossRef]
- Parafati, L.; Vitale, A.; Restuccia, C.; Cirvilleri, G. Biocontrol Ability and Action Mechanism of Food-Isolated Yeast Strains against Botrytis Cinerea Causing Post-Harvest Bunch Rot of Table Grape. Food Microbiol. 2015, 47, 85–92. [Google Scholar] [CrossRef]
- Einloft, T.C.; Bolzan de Oliveira, P.; Radünz, L.L.; Dionello, R.G. Biocontrol Capabilities of Three Bacillus Isolates towards Aflatoxin B1 Producer A. Flavus in vitro and on Maize Grains. Food Control 2021, 125, 107978. [Google Scholar] [CrossRef]
- Kong, Q.; Shan, S.; Liu, Q.; Wang, X.; Yu, F. Biocontrol of Aspergillus flavus on Peanut Kernels by Use of a Strain of Marine Bacillus Megaterium. Int. J. Food Microbiol. 2010, 139, 31–35. [Google Scholar] [CrossRef] [PubMed]
- Accinelli, C.; Mencarelli, M.; Saccà, M.L.; Vicari, A.; Abbas, H.K. Managing and Monitoring of Aspergillus flavus in Corn Using Bioplastic-Based Formulations. Crop Prot. 2012, 32, 30–35. [Google Scholar] [CrossRef]
- Yan, W.; Gao, H.; Qian, X.; Jiang, Y.; Zhou, J.; Dong, W.; Xin, F.; Zhang, W.; Jiang, M. Biotechnological Applications of the Non-Conventional Yeast Meyerozyma Guilliermondii. Biotechnol. Adv. 2021, 46, 107674. [Google Scholar] [CrossRef]
- Medina-Córdova, N.; López-Aguilar, R.; Ascencio, F.; Castellanos, T.; Campa-Córdova, A.I.; Angulo, C. Biocontrol Activity of the Marine Yeast Debaryomyces Hansenii against Phytopathogenic Fungi and Its Ability to Inhibit Mycotoxins Production in Maize Grain (Zea mays L.). Biol. Control 2016, 97, 70–79. [Google Scholar] [CrossRef]
- Liu, Y.; Yao, S.; Deng, L.; Ming, J.; Zeng, K. Different Mechanisms of Action of Isolated Epiphytic Yeasts against Penicillium Digitatum and Penicillium Italicum on Citrus Fruit. Postharvest Biol. Technol. 2019, 152, 100–110. [Google Scholar] [CrossRef]
- Tryfinopoulou, P.; Chourdaki, A.; Nychas, G.J.E.; Panagou, E.Z. Competitive Yeast Action against Aspergillus carbonarius Growth and Ochratoxin A Production. Int. J. Food Microbiol. 2020, 317, 108460. [Google Scholar] [CrossRef]
- Pantelides, I.S.; Christou, O.; Tsolakidou, M.D.; Tsaltas, D.; Ioannou, N. Isolation, Identification and in vitro Screening of Grapevine Yeasts for the Control of Black Aspergilli on Grapes. Biol. Control 2015, 88, 46–53. [Google Scholar] [CrossRef]
- Farbo, M.G.; Urgeghe, P.P.; Fiori, S.; Marcello, A.; Oggiano, S.; Balmas, V.; Hassan, Z.U.; Jaoua, S.; Migheli, Q. Effect of Yeast Volatile Organic Compounds on Ochratoxin A-Producing Aspergillus carbonarius and A. Ochraceus. Int. J. Food Microbiol. 2018, 284, 1–10. [Google Scholar] [CrossRef] [PubMed]
- Ruiz-Moyano, S.; Hernández, A.; Galvan, A.I.; Córdoba, M.G.; Casquete, R.; Serradilla, M.J.; Martín, A. Selection and Application of Antifungal VOCs-Producing Yeasts as Biocontrol Agents of Grey Mould in Fruits. Food Microbiol. 2020, 92, 103556. [Google Scholar] [CrossRef]
- Huang, Y.; Sun, C.; Guan, X.; Lian, S.; Li, B.; Wang, C. Biocontrol Efficiency of Meyerozyma Guilliermondii Y-1 against Apple Postharvest Decay Caused by Botryosphaeria Dothidea and the Possible Mechanisms of Action. Int. J. Food Microbiol. 2021, 338, 108957. [Google Scholar] [CrossRef]
- Di Francesco, A.; Di Foggia, M.; Baraldi, E. Aureobasidium Pullulans Volatile Organic Compounds as Alternative Postharvest Method to Control Brown Rot of Stone Fruits. Food Microbiol. 2020, 87, 103395. [Google Scholar] [CrossRef]
- Lino de Souza, M.; Silva Ribeiro, L.; Gabriela da Cruz Pedrozo Miguel, M.; Roberto Batista, L.; Freitas Schwan, R.; Henrique Medeiros, F.; Ferreira Silva, C. Yeasts Prevent Ochratoxin A Contamination in Coffee by Displacing Aspergillus carbonarius. Biol. Control 2021, 155, 104512. [Google Scholar] [CrossRef]
- Ponsone, M.L.; Nally, M.C.; Chiotta, M.L.; Combina, M.; Köhl, J.; Chulze, S.N. Evaluation of the Effectiveness of Potential Biocontrol Yeasts against Black Sur Rot and Ochratoxin A Occurring under Greenhouse and Field Grape Production Conditions. Biol. Control 2016, 103, 78–85. [Google Scholar] [CrossRef]
- Saravanakumar, D.; Ciavorella, A.; Spadaro, D.; Garibaldi, A.; Gullino, M.L. Metschnikowia Pulcherrima Strain MACH1 Outcompetes Botrytis Cinerea, Alternaria Alternata and Penicillium Expansum in Apples through Iron Depletion. Postharvest Biol. Technol. 2008, 49, 121–128. [Google Scholar] [CrossRef]
- Zhimo, V.Y.; Kumar, A.; Biasi, A.; Salim, S.; Feygenberg, O.; Toamy, M.A.; Abdelfattaah, A.; Medina, S.; Freilich, S.; Wisniewski, M.; et al. Compositional Shifts in the Strawberry Fruit Microbiome in Response to Near-Harvest Application of Metschnikowia Fructicola, a Yeast Biocontrol Agent. Postharvest Biol. Technol. 2021, 175, 111469. [Google Scholar] [CrossRef]
- Lahlali, R.; Hamadi, Y.; Drider, R.; Misson, C.; El Guilli, M.; Jijakli, M.H. Control of Citrus Blue Mold by the Antagonist Yeast Pichia Guilliermondii Z1: Compatibility with Commercial Fruit Waxes and Putative Mechanisms of Action. Food Control 2014, 45, 8–15. [Google Scholar] [CrossRef]
- Yang, Q.; Ma, J.; Solairaj, D.; Fu, Y.; Zhang, H. Efficacy of Meyerozyma Guilliermondii in Controlling Patulin Production by Penicillium Expansum in Shuijing Pears. Biol. Control 2022, 168, 104856. [Google Scholar] [CrossRef]
- Wang, Z.; Li, J.; Liu, J.; Tian, X.; Zhang, D.; Wang, Q. Management of Blue Mold (Penicillium Italicum) on Mandarin Fruit with a Combination of the Yeast, Meyerozyma Guilliermondii and an Alginate Oligosaccharide. Biol. Control 2021, 152, 104451. [Google Scholar] [CrossRef]
- Öztekin, S.; Karbancioglu-Guler, F. Biological Control of Green Mould on Mandarin Fruit through the Combined Use of Antagonistic Yeasts. Biol. Control 2023, 180, 105186. [Google Scholar] [CrossRef]
- Millan, A.F.; Fernandez-irigoyen, J.; Larraya, L.; Farran, I.; Veramendi, J. Metschnikowia Pulcherrima as an Efficient Biocontrol Agent of Botrytis Cinerea Infection in Apples: Unraveling Protection Mechanisms through Yeast Proteomics. Biol. Control 2023, 183, 105266. [Google Scholar] [CrossRef]
- Cheng, L.; Zhou, L.; Li, D.; Gao, Z.; Teng, J.; Nie, X.; Guo, F.; Wang, C.; Wang, X.; Li, S.; et al. Combining the Biocontrol Agent Meyerozyma Guilliermondii with UV-C Treatment to Manage Postharvest Gray Mold on Kiwifruit. Biol. Control 2023, 180, 105198. [Google Scholar] [CrossRef]
- Parafati, L.; Restuccia, C.; Cirvilleri, G. Efficacy and Mechanism of Action of Food Isolated Yeasts in the Control of Aspergillus flavus Growth on Pistachio Nuts. Food Microbiol. 2022, 108, 104100. [Google Scholar] [CrossRef]
- Sen, Y.; Onal-Ulusoy, B.; Mutlu, M. Aspergillus Decontamination in Hazelnuts: Evaluation of Atmospheric and Low-Pressure Plasma Technology. Innov. Food Sci. Emerg. Technol. 2019, 54, 235–242. [Google Scholar] [CrossRef]
- Dasan, B.G.; Boyaci, I.H.; Mutlu, M. Nonthermal Plasma Treatment of Aspergillus spp. Spores on Hazelnuts in an Atmospheric Pressure Fluidized Bed Plasma System: Impact of Process Parameters and Surveillance of the Residual Viability of Spores. J. Food Eng. 2017, 196, 139–149. [Google Scholar] [CrossRef]
- Sen, Y.; Onal-Ulusoy, B.; Mutlu, M. Detoxification of Hazelnuts by Different Cold Plasmas and Gamma Irradiation Treatments. Innov. Food Sci. Emerg. Technol. 2019, 54, 252–259. [Google Scholar] [CrossRef]
- Mošovská, S.; Medvecká, V.; Gregová, M.; Tomeková, J.; Valík, Ľ.; Mikulajová, A.; Zahoranová, A. Plasma Inactivation of Aspergillus flavus on Hazelnut Surface in a Diffuse Barrier Discharge Using Different Working Gases. Food Control 2019, 104, 256–261. [Google Scholar] [CrossRef]
- Oztekin, S.; Karbancioglu-Guler, F. Bioprospection of Metschnikowia sp. Isolates as Biocontrol Agents against Postharvest Fungal Decays on Lemons with Their Potential Modes of Action. Postharvest Biol. Technol. 2021, 181, 111634. [Google Scholar] [CrossRef]
- Saitou, N.; Nei, M. The Neighbor-Joining Method: A New Method for Reconstructing Phylogenetic Trees. Mol. Biol. Evol. 1987, 4, 406–425. [Google Scholar] [CrossRef]
- Tamura, K.; Nei, M.; Kumar, S. Prospects for Inferring Very Large Phylogenies by Using the Neighbor-Joining Method. Proc. Natl. Acad. Sci. USA 2004, 101, 11030–11035. [Google Scholar] [CrossRef]
- Kumar, S.; Stecher, G.; Li, M.; Knyaz, C.; Tamura, K. MEGA X: Molecular Evolutionary Genetics Analysis across Computing Platforms. Mol. Biol. Evol. 2018, 35, 1547–1549. [Google Scholar] [CrossRef]
- Zhu, C.; Shi, J.; Jiang, C.; Liu, Y. Inhibition of the Growth and Ochratoxin A Production by Aspergillus carbonarius and Aspergillus ochraceus in vitro and in vivo through Antagonistic Yeasts. Food Control 2015, 50, 125–132. [Google Scholar] [CrossRef]
- Fiori, S.; Urgeghe, P.P.; Hammami, W.; Razzu, S.; Jaoua, S.; Migheli, Q. Biocontrol Activity of Four Non- and Low-Fermenting Yeast Strains against Aspergillus carbonarius and Their Ability to Remove Ochratoxin A from Grape Juice. Int. J. Food Microbiol. 2014, 189, 45–50. [Google Scholar] [CrossRef] [PubMed]
- Rushing, B.R.; Selim, M.I. Aflatoxin B1: A Review on Metabolism, Toxicity, Occurrence in Food, Occupational Exposure, and Detoxification Methods. Food Chem. Toxicol. 2019, 124, 81–100. [Google Scholar] [CrossRef] [PubMed]
- Palumbo, J.D.; Baker, J.L.; Mahoney, N.E. Isolation of Bacterial Antagonists of Aspergillus flavus from Almonds. Microb. Ecol. 2006, 52, 45–52. [Google Scholar] [CrossRef]
- Dorner, J.W. Biological Control of Aflatoxin Contamination of Crops. J. Toxicol. Toxin Rev. 2004, 23, 425–450. [Google Scholar] [CrossRef]
- Spadaro, D.; Lorè, A.; Garibaldi, A.; Gullino, M.L. A New Strain of Metschnikowia Fructicola for Postharvest Control of Penicillium Expansum and Patulin Accumulation on Four Cultivars of Apple. Postharvest Biol. Technol. 2013, 75, 1–8. [Google Scholar] [CrossRef]
- Rodriguez Assaf, L.A.; Pedrozo, L.P.; Nally, M.C.; Pesce, V.M.; Toro, M.E.; Castellanos de Figueroa, L.I.; Vazquez, F. Use of Yeasts from Different Environments for the Control of Penicillium Expansum on Table Grapes at Storage Temperature. Int. J. Food Microbiol. 2020, 320, 108520. [Google Scholar] [CrossRef]
- Fernandez-San Millan, A.; Larraya, L.; Farran, I.; Ancin, M.; Veramendi, J. Successful Biocontrol of Major Postharvest and Soil-Borne Plant Pathogenic Fungi by Antagonistic Yeasts. Biol. Control 2021, 160, 104683. [Google Scholar] [CrossRef]
- Banani, H.; Spadaro, D.; Zhang, D.; Matic, S.; Garibaldi, A.; Gullino, M.L. Postharvest Application of a Novel Chitinase Cloned from Metschnikowia Fructicola and Overexpressed in Pichia Pastoris to Control Brown Rot of Peaches. Int. J. Food Microbiol. 2015, 199, 54–61. [Google Scholar] [CrossRef] [PubMed]
- Kulakovskaya, T.V.; Shashkov, A.S.; Kulakovskaya, E.V.; Golubev, W.I. Ustilagic Acid Secretion by Pseudozyma Fusiformata Strains. FEMS Yeast Res. 2005, 5, 919–923. [Google Scholar] [CrossRef] [PubMed]
- Golubev, W.I.; Kulakovskaya, T.V.; Shashkov, A.S.; Kulakovskaya, E.V.; Golubev, N.V. Antifungal Cellobiose Lipid Secreted by the Epiphytic Yeast Pseudozyma Graminicola. Microbiology 2008, 77, 171–175. [Google Scholar] [CrossRef]
- Cordero-Bueso, G.; Mangieri, N.; Maghradze, D.; Foschino, R.; Valdetara, F.; Cantoral, J.M.; Vigentini, I. Wild Grape-Associated Yeasts as Promising Biocontrol Agents against Vitis Vinifera Fungal Pathogens. Front. Microbiol. 2017, 8, 2025. [Google Scholar] [CrossRef]
- Agirman, B.; Erten, H. Biocontrol Ability and Action Mechanisms of Aureobasidium Pullulans GE17 and Meyerozyma Guilliermondii KL3 against Penicillium Digitatum DSM2750 and Penicillium Expansum DSM62841 Causing Postharvest Diseases. Yeast 2020, 37, 437–448. [Google Scholar] [CrossRef]
- Moore, G.G.; Lebar, M.D.; Carter-Wientjes, C.H.; Gilbert, M.K. The Potential Role of Fungal Volatile Organic Compounds in Aspergillus flavus Biocontrol Efficacy. Biol. Control 2021, 160, 104686. [Google Scholar] [CrossRef]
- Oro, L.; Feliziani, E.; Ciani, M.; Romanazzi, G.; Comitini, F. Volatile Organic Compounds from Wickerhamomyces Anomalus, Metschnikowia Pulcherrima and Saccharomyces Cerevisiae Inhibit Growth of Decay Causing Fungi and Control Postharvest Diseases of Strawberries. Int. J. Food Microbiol. 2018, 265, 18–22. [Google Scholar] [CrossRef] [PubMed]
- Ul Hassan, Z.; Al Thani, R.; Atia, F.A.; Alsafran, M.; Migheli, Q.; Jaoua, S. Application of Yeasts and Yeast Derivatives for the Biological Control of Toxigenic Fungi and Their Toxic Metabolites. Environ. Technol. Innov. 2021, 22, 101447. [Google Scholar] [CrossRef]
- Contarino, R.; Brighina, S.; Fallico, B.; Cirvilleri, G.; Parafati, L.; Restuccia, C. Volatile Organic Compounds (VOCs) Produced by Biocontrol Yeasts. J. Food Microbiol. 2019, 82, 70–74. [Google Scholar] [CrossRef]
- Al-Maawali, S.S.; Al-Sadi, A.M.; Ali Khalifa Alsheriqi, S.; Nasser Al-Sabahi, J.; Velazhahan, R. The Potential of Antagonistic Yeasts and Bacteria from Tomato Phyllosphere and Fructoplane in the Control of Alternaria Fruit Rot of Tomato. All Life 2021, 14, 34–48. [Google Scholar] [CrossRef]
- Shude, S.P.N.; Mbili, N.C.; Yobo, K.S. Epiphytic Yeasts as Potential Antagonists against Fusarium Head Blight of Wheat (Triticum aestivum L.) Caused by Fusarium Graminearum Sensu Strict. J. Saudi Soc. Agric. Sci. 2021, 21, 404–411. [Google Scholar] [CrossRef]
- Pawlikowska, E.; James, S.A.; Breierova, E.; Antolak, H.; Kregiel, D. Biocontrol Capability of Local Metschnikowia sp. Isolates. Antonie Van Leeuwenhoek 2019, 112, 1425–1445. [Google Scholar] [CrossRef] [PubMed]
- Patharajan, S.; Reddy, K.R.N.; Karthikeyan, V.; Spadaro, D.; Lore, A.; Gullino, M.L.; Garibaldi, A. Potential of Yeast Antagonists on Invitro Biodegradation of Ochratoxin A. Food Control 2011, 22, 290–296. [Google Scholar] [CrossRef]
- Spadaro, D.; Droby, S. Development of Biocontrol Products for Postharvest Diseases of Fruit: The Importance of Elucidating the Mechanisms of Action of Yeast Antagonists. Trends Food Sci. Technol. 2016, 47, 39–49. [Google Scholar] [CrossRef]
- Settier-Ramírez, L.; López-Carballo, G.; Hernández-Muñoz, P.; Fontana, A.; Strub, C.; Schorr-Galindo, S. New Isolated Metschnikowia pulcherrima Strains from Apples for Postharvest Biocontrol of Penicillium expansum and Patulin Accumulation. Toxins 2021, 13, 397. [Google Scholar] [CrossRef]
- Siahmoshteh, F.; Siciliano, I.; Banani, H.; Hamidi-Esfahani, Z.; Razzaghi-Abyaneh, M.; Gullino, M.L.; Spadaro, D. Efficacy of Bacillus Subtilis and Bacillus Amyloliquefaciens in the Control of Aspergillus Parasiticus Growth and Aflatoxins Production on Pistachio. Int. J. Food Microbiol. 2017, 254, 47–53. [Google Scholar] [CrossRef]
- Zhang, J.; Wang, Y.; Du, Z.; Lin, D.; Huo, L.; Qin, L.; Wang, W.; Qiang, L.; Yao, Y.; An, Y. Screening, Identification and Antagonistic Effect of Antagonistic Bacteria JTFM1001 against Aflatoxin Contamination in Corn. Oil Crop Sci. 2021, 6, 1–7. [Google Scholar] [CrossRef]
- Bragulat, M.R.; Abarca, M.L.; Cabañes, F.J. An Easy Screening Method for Fungi Producing Ochratoxin A in Pure Culture. Int. J. Food Microbiol. 2001, 71, 139–144. [Google Scholar] [CrossRef]
Disclaimer/Publisher’s Note: The statements, opinions and data contained in all publications are solely those of the individual author(s) and contributor(s) and not of MDPI and/or the editor(s). MDPI and/or the editor(s) disclaim responsibility for any injury to people or property resulting from any ideas, methods, instructions or products referred to in the content. |
© 2023 by the authors. Licensee MDPI, Basel, Switzerland. This article is an open access article distributed under the terms and conditions of the Creative Commons Attribution (CC BY) license (https://creativecommons.org/licenses/by/4.0/).